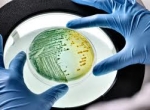

A.V.M, Catecolaminas Urinarias
DURANTE LOS TRES DÍAS PREVIOS A LA REALIZACIÓN DEL ANÁLISIS, EL PACIENTE DEBERÁ SUPRIMIR LA INGESTIÓN DE : TE, CAFÉ, MATE, CHOCOLATE, VAINILLA, (ALIMENTOS QUE LA CONTENGAN COMO: POSTRES, HELADOS, ETC.), ALCOHOL, BANANAS, TOMATE, NUECES, PALTAS, CIRUELAS, ANANÁ, BERENGENAS. AL CUARTO DÍA, CONTINUANDO CON LA DIETA, RECOGER ORINA DE 24 HORAS EN RECIPIENTE DE PLÁSTICO. CONSERVAR LA MUESTRA EN HELADERA.